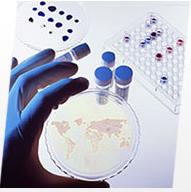

高压蒸汽灭菌器利用压力饱和蒸汽对产品进行迅速而可靠的消毒灭菌,由于灭菌效果可靠,成本低,备受各类实验室用户的青睐,下面乐鱼(中国)就为大家介绍高压蒸汽灭菌器的6类用途。
1、玻璃器皿灭菌

玻璃器皿灭菌是常见的灭菌对象之,化验室、微生物实验室、细胞室等等都会有玻璃器皿需要灭菌。常用容积50L,75L。灭菌器时间、温度可控节省人力。
2、手术器械灭菌

手术器械灭菌器在医疗行业属于常见的灭菌对象,由于接触人体所以对灭菌效果有很高的要求,冷空气排放是否彻底对灭菌效果有很大的影响,乐鱼(中国)乐鱼在线登录官网具备1-9次正压脉动排气功能,多次排气能彻底排除冷空气,保证灭菌效果。
3、敷料灭菌

敷料灭菌对干燥有定要求,如果想彻底干燥普通高压蒸汽灭菌器已经满足不了您的要求了,需要选择款“脉动真空高压蒸汽灭菌器”。如果对干燥效果要求不是特别严格,乐鱼(中国)乐鱼在线登录官网,在普通机器中干燥效果绝对强。
4、培养基灭菌
培养基灭菌在微生物实验室很常见,培养基多数为固态,想要灭菌先需要溶解,溶解之后进行灭菌,然后进行保温处理,才能达到好的灭菌效果,乐鱼(中国)灭菌器具备单独的培养基灭菌程序,再也不用为培养基灭菌发愁了。
5、液体灭菌

液体灭菌对排气方式有定要求,如果灭菌完成迅速排放蒸汽,会使玻璃瓶爆裂。需要选择款慢排气功能的机器,才能保证灭菌完成不会发生涨瓶现象。乐鱼(中国)高压蒸汽灭菌器依然具备慢排气装置,并且具备液体灭菌程序,键操作轻松灭菌。
6、真空包装食品

真空包装的食品为了延长质保期,杀灭大肠杆菌也需进行高温灭菌,如果您购买机器是此种用途,那和液体灭菌样,也需要注意排气功能的选择,避免发生涨袋现象。
相关阅读:乐鱼在线登录官网







